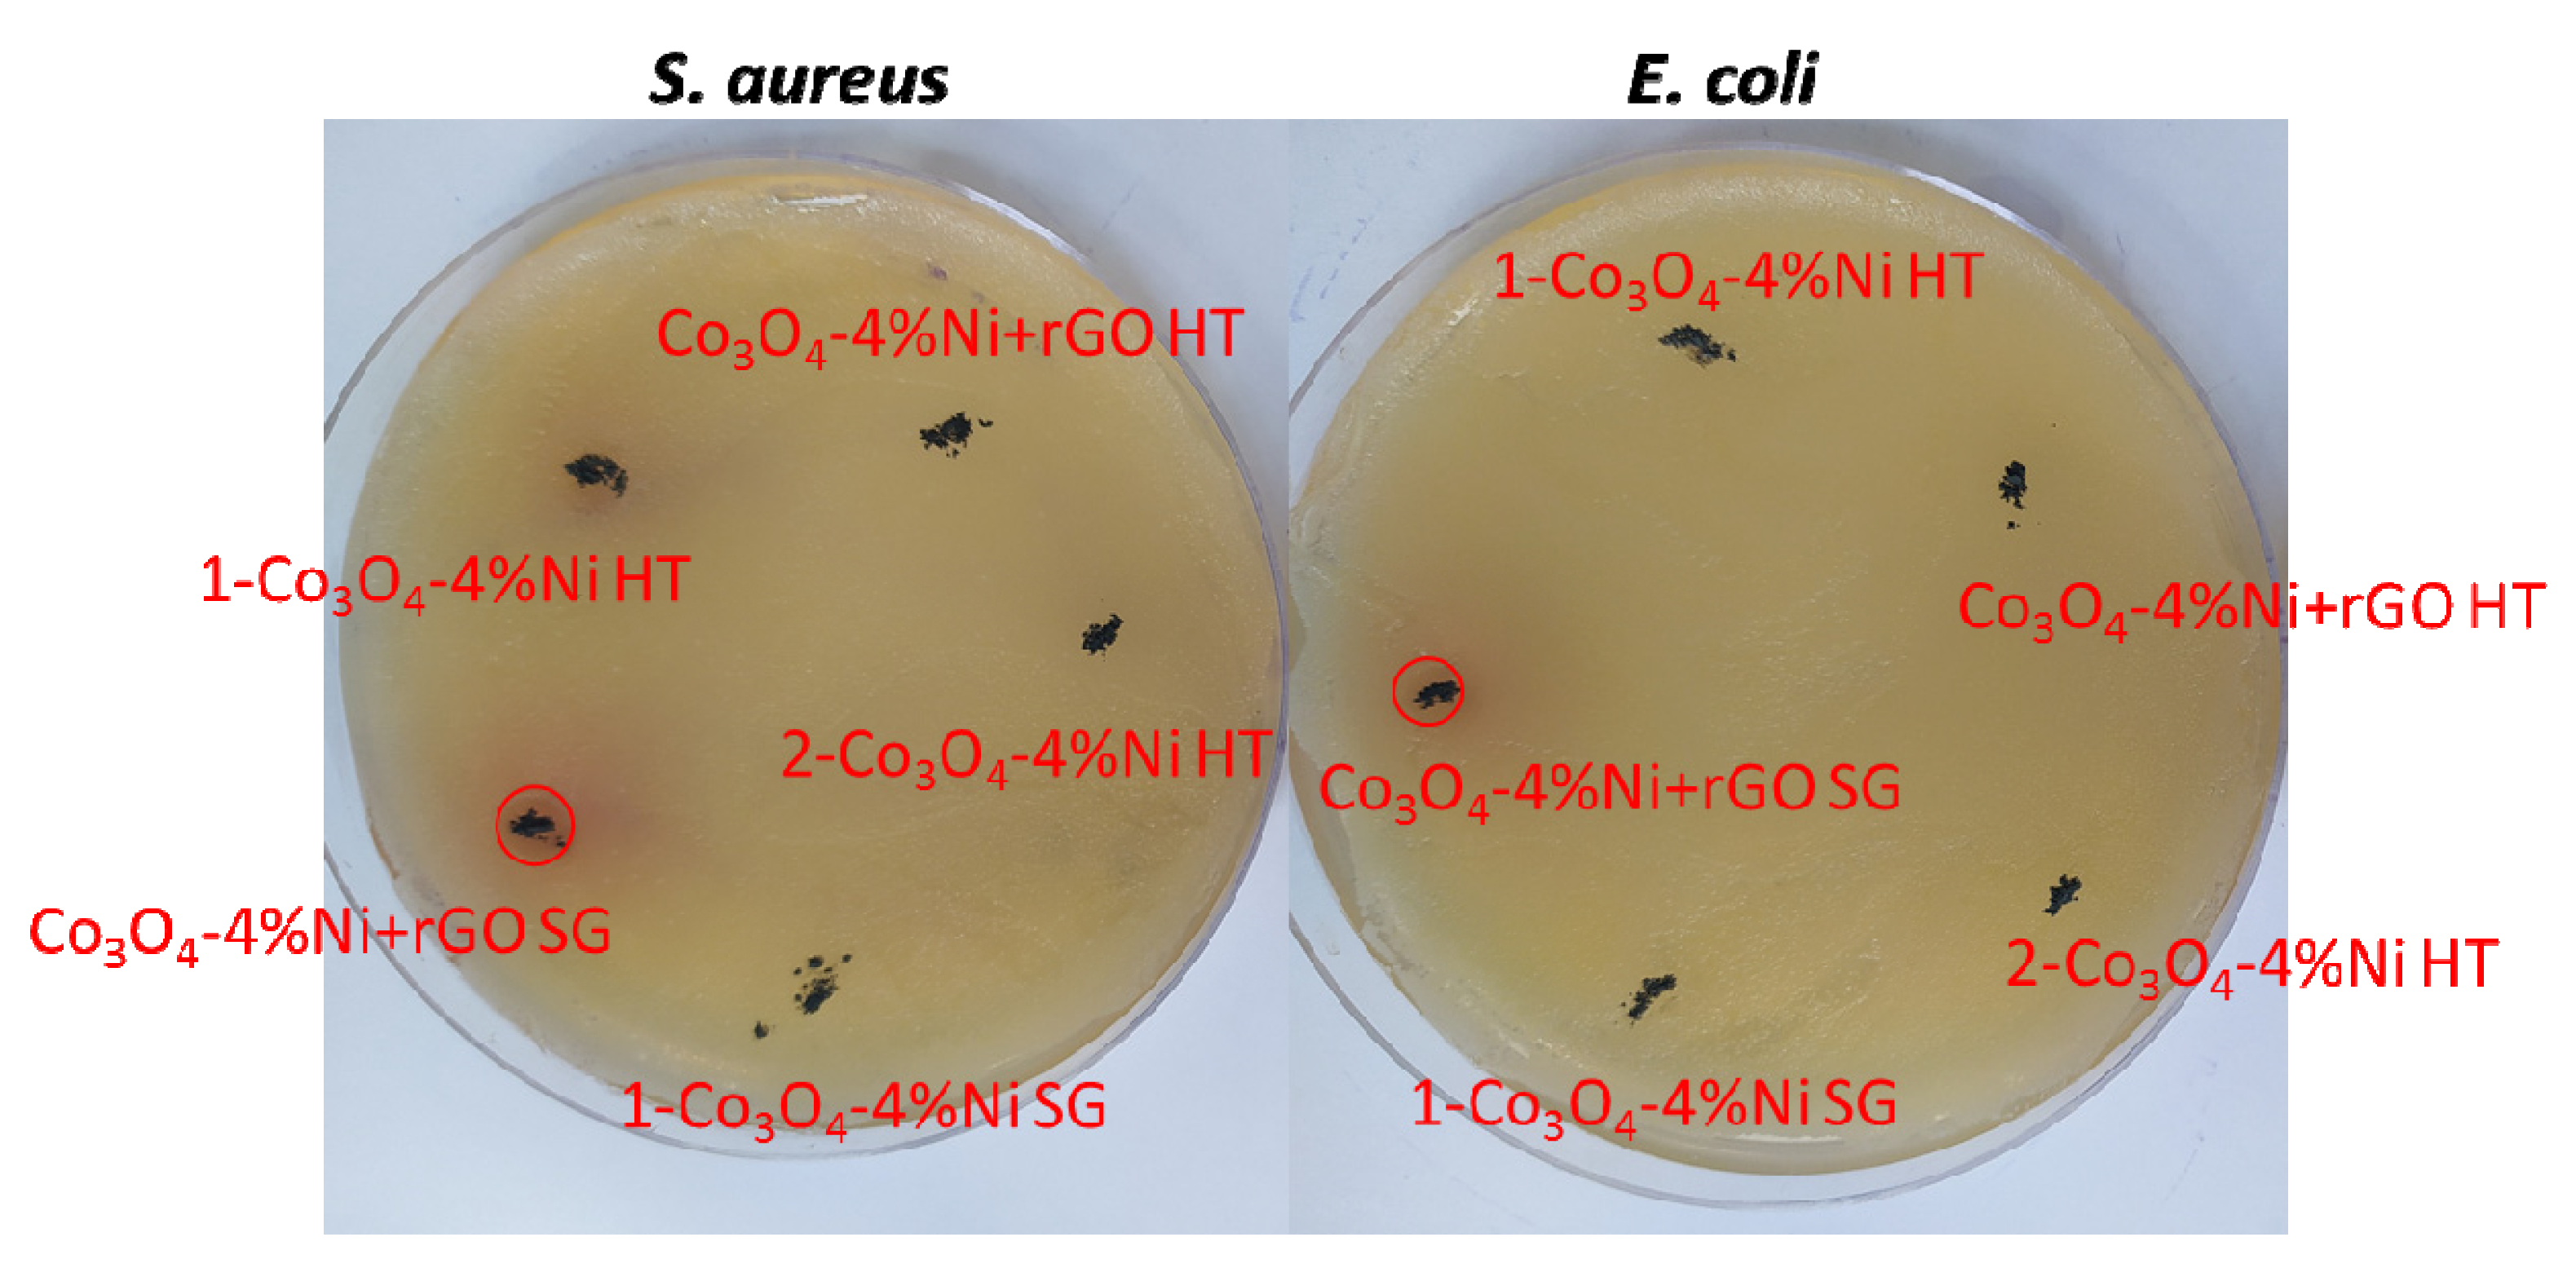
Catalysts 12 01199 g007

Evaluation of Ni-Doped Tricobalt Tetroxide with Reduced Graphene Oxide: Structural, Photocatalysis, and Antibacterial Response
Abstract
1. Introduction
2. Results
2.1. Characterization of the Samples
2.2. Antibacterial Activity
2.3. Photocatalytic Activity
3. Materials and Methods
3.1. Synthesis
3.1.1. Bactericidal Test: Agar Diffusion
3.1.2. Photocatalytic Tests
3.2. Characterizations
4. Conclusions
Author Contributions
Funding
Data Availability Statement
Acknowledgments
Conflicts of Interest
References
- Chen, H.; Xue, C.; Cui, D.; Liu, M.; Chen, Y.; Li, Y.; Zhang, W. Co3O4–Ag photocatalysts for the efficient degradation of methyl orange. RSC Adv. 2020, 10, 15245–15251. [Google Scholar] [CrossRef] [PubMed]
- Sanakousar, M.F.; Jiménez-Pérez, V.M.; Shridhar, A.H. Mechanistic insight into the photocatalytic degradation of organic pollutants and electrochemical behavior of modified MWCNTs/Cu–Co3O4 nanocomposites. React. Chem. Eng. 2022, 7, 1847–1872. [Google Scholar] [CrossRef]
- Wang, X.; Lu, S.; Xu, W. Synthesis of Needle-like Nanostructure Composite Electrode of Co3O4/rGO/NF for High-Performance Symmetric Supercapacitor. Crystals 2022, 12, 664. [Google Scholar] [CrossRef]
- Chun, L.; Shuai, M.; Mingxing, S.; Fengyun, W.; Mingzhu, X.; Qun, C.; Xuehai, J. Peroxymonosulfate activation through 2D/2D Z-scheme CoAl-LDH/BiOBr photocatalyst under visible light for ciprofloxacin degradation. J. Hazard. Mater. 2021, 420, 126613. [Google Scholar] [CrossRef]
- Chun, L.; Shuai, M.; Mingxing, S.; Xianyong, H.; Dongting, W.; Fengyun, W.; Mingzhu, X.; Qun, C. Enhanced photocatalytic degradation performance of BiVO4/BiOBr through combining Fermi level alteration and oxygen defect engineering. Chem. Eng. J. 2022, 449, 137757. [Google Scholar] [CrossRef]
- Awais, A.; Safia, K.; Sadaf, T.; Rafael, L.; Francis, V. Self-sacrifice MOFs for heterogeneous catalysis: Synthesis mechanisms and future perspectives. Mater. Today 2022, 55, 137–169. [Google Scholar] [CrossRef]
- Madhura, T.R.; Kumar, G.G.; Ramaraj, R. Reduced graphene oxide-supported Co3O4 nanocomposite bifunctional electrocatalysts for glucose–oxygen fuel cells. Energy Fuels 2020, 34, 12984–12994. [Google Scholar] [CrossRef]
- Cardenas-Flechas, L.J.; Freire, P.T.C.; Paris, E.C.; Moreno, L.C.; Joya, M.R. Temperature-induced structural phase transformation in samples of Co3O4 and Co3-xNixO4 for CoO. Materialia 2021, 18, 101155. [Google Scholar] [CrossRef]
- Rehman, A.U.; Fayaz, M.; Lv, H.; Liu, Y.; Zhang, J.; Wang, Y.; Shi, K. Controllable Synthesis of a Porous PEI-Functionalized Co3O4/rGO Nanocomposite as an Electrochemical Sensor for Simultaneous as Well as Individual Detection of Heavy Metal Ions. ACS Omega 2022, 7, 5870–5882. [Google Scholar] [CrossRef]
- Mussa, Y.; Ahmed, F.; Abuhimd, H.; Arsalan, M.; Alsharaeh, E. Enhanced Electrochemical performance at high temperature of Cobalt Oxide/Reduced Graphene Oxide Nanocomposites and its application in lithium-ion batteries. Sci. Rep. 2019, 9, 44. [Google Scholar] [CrossRef]
- Elaine, C.P.; João, O.D.M.; Ailton, J.M.; Lílian, C.S.; Camila, R.S.; Alessandra, Z.; Márcia, T.E.; Valmor, R.M.; Miryam, R.J. CuO nanoparticles decorated on hydroxyapatite/ferrite magnetic support: Photocatalysis, cytotoxicity, and antimicrobial response. Environ. Sci. Pollut. Res. 2021, 29, 41505–41519. [Google Scholar] [CrossRef]
- Ozkaya, T.; Baykal, A.; Toprak, M.S.; Koseoğlu, Y.; Durmuş, Z. Reflux synthesis of Co3O4 nanoparticles and its magnetic characterization. J. Magn. Magn. Mater. 2009, 321, 2145–2149. [Google Scholar] [CrossRef]
- Manoratne, C.H.; Rosa, S.; Kottegoda, I.R.M. XRD-HTA, UV visible, FTIR and SEM interpretation of reduced graphene oxide synthesized from high purity vein graphite. Mater. Sci. Res. India 2017, 14, 19–30. [Google Scholar] [CrossRef]
- Aluiz, A.M.A.D.; da Silva, K.S.; Araújo, M.K.S.; Sales, D.C.S.; Ferreira, M.C.; de Araújo, A.C.V.; de Azevedo, W.M.; Falcão, E.H.L. Thermal synthesis of rGO and rGO-Co3O4 and their application as adsorbents for anionic dye removal. Colloids Surf. A Physicochem. Eng. Asp. 2020, 599, 124837. [Google Scholar] [CrossRef]
- Thota, S.; Kumar, A.; Kumar, J. Optical, electrical and magnetic properties of Co3O4 nanocrystallites obtained by thermal decomposition of sol–gel derived oxalates. J. Mater. Sci. Eng. B 2009, 164, 30–37. [Google Scholar] [CrossRef]
- Jiang, Y.L.; Dan, W.; Min, W.; Dejia, K.; Yi, Z.; Jian-Feng, C.; Liming, D. Two-Dimensional Co3O4 Porous Sheets: Facile Synthesis and Enhanced Photocatalytic Performance. Chem. Eng. Technol. 2016, 39, 891–898. [Google Scholar] [CrossRef]
- Shi, H.; Chen, G.; Zhang, C.; Zou, Z. Polymeric g-C3N4 Coupled with NaNbO3 Nanowires toward Enhanced Photocatalytic Reduction of CO2 into Renewable Fuel. ACS Catal. 2014, 4, 3637–3643. [Google Scholar] [CrossRef]
- Angela, M.R.-P.; João, O.D.M.; Carlos, A.P.V.; Elaine, C.P.; Miryam, R.J. Structural evolution, optical properties, and photocatalytic performance of copper and tungsten heterostructure materials. Mater. Today Commun. 2021, 26, 101886. [Google Scholar] [CrossRef]
- Alsharaeh, E.; Mussa, Y.; Ahmed, F.; Aldawsari, Y.; Al-Hindawi, M.; Sing, G.K. Novel route for the preparation of cobalt oxide nanoparticles/reduced graphene oxide nanocomposites and their antibacterial activities. Ceram. Int. 2016, 42, 3407–3410. [Google Scholar] [CrossRef]
- Gnanamoorthy, G.; Priya, P.; Ali, D.; Lakshmi, M.; Yadav, V.K.; Varghese, R. A new CuZr2S4/rGO and their reduced graphene oxide nanocomposities enhanced photocatalytic and antimicrobial activities. Chem. Phys. Lett. 2021, 781, 139011. [Google Scholar] [CrossRef]
- Elbasuney, S.; El-Sayyad, G.S.; Tantawy, H.; Hashem, A.H. Promising antimicrobial and antibiofilm activities of reduced graphene oxide-metal oxide (RGO-NiO, RGO-AgO, and RGO-ZnO) nanocomposites. RSC Adv. 2021, 11, 25961–25975. [Google Scholar] [CrossRef] [PubMed]
- Alayande, A.B.; Obaid, M.; Kim, I.S. Antimicrobial mechanism of reduced graphene oxide-copper oxide (rGO-CuO) nanocomposite films: The case of Pseudomonas aeruginosa PAO1. Mater. Sci. Eng. C. 2020, 109, 110596. [Google Scholar] [CrossRef] [PubMed]
- Malafatti, J.O.; Moreira, A.J.; Sciena, C.R.; Silva, T.E.; Freschi, G.P.; Pereira, E.C.; Paris, E.C. Prozac® removal promoted by HAP: Nb2O5 nanoparticles system: By-products, mechanism, and cytotoxicity assessment. J. Environ. Chem. Eng. 2021, 9, 104820. [Google Scholar] [CrossRef]
- Moreira, A.J.; Coelho, D.; Dias, J.A.; Mascaro, L.H.; Freschi, G.P.; Mastelaro, V.R.; Pereira, E.C. Phase control and optimization of photocatalytic properties of samarium doped TiO2 synthesized by coupled ultraviolet and microwave radiations. J. Alloys Compd. 2022, 905, 164217. [Google Scholar] [CrossRef]
- Moreira, A.J.; Lemos, S.G.; Coelho, D.; Mascaro, L.H.; Freschi, G.P.; Pereira, E.C. UV–Vis spectrophotometry coupled to chemometric analysis for the performance evaluation of atrazine photolysis and photocatalysis. Environ. Sci. Pollut. Res. 2022, 29, 24010–24023. [Google Scholar] [CrossRef]
- Cardenas-Flechas, L.J.; Raba, A.M.; Rincón-Joya, M. Synthesis and evaluation of nickel doped Co3O4 produced through hydrothermal technique. Dyna 2020, 87, 184–191. [Google Scholar] [CrossRef]
- Jin, L.; Li, X.; Ming, H.; Wang, H.; Jia, Z.; Fu, Y.; Zheng, J. Hydrothermal synthesis of Co3O4 with different morphologies towards efficient Li-ion storage. RSC Adv. 2014, 4, 6083–6089. [Google Scholar] [CrossRef]

| Samples | Eg (eV) | Conduction Band (CB) (eV) | Valence Band (VB) (eV) |
|---|---|---|---|
| 2Co3O4-4%Ni HT | 2.24 | 0.28 | 2.52 |
| 1Co3O4-4%Ni HT | 2.80 | 0.00 | 2.80 |
| Co3O4-4%Ni SG | 2.15 | 0.33 | 2.48 |
| Co3O4-4%Ni+rGO SG | 2.00 | 0.40 | 2.40 |
| Material | S. aureus/mm | E. coli/mm |
|---|---|---|
| Co3O4-4%Ni SG | - | - |
| 1-Co3O4-4%Ni HT | - | - |
| 2-Co3O4-4%Ni HT | - | - |
| Co3O4-4%Ni+rGO HT | - | - |
| Co3O4-4%Ni+rGO SG | 0.72 ± 0.02 | 0.47± |
Publisher’s Note: MDPI stays neutral with regard to jurisdictional claims in published maps and institutional affiliations. |
© 2022 by the authors. Licensee MDPI, Basel, Switzerland. This article is an open access article distributed under the terms and conditions of the Creative Commons Attribution (CC BY) license (https://creativecommons.org/licenses/by/4.0/).
Share and Cite
Malafatti, J.O.D.; Moreira, A.J.; Paris, E.C.; Cardenas Flechas, L.J.; Pereira, O.A.P.; Rincón Joya, M. Evaluation of Ni-Doped Tricobalt Tetroxide with Reduced Graphene Oxide: Structural, Photocatalysis, and Antibacterial Response. Catalysts 2022, 12, 1199. https://doi.org/10.3390/catal12101199
Malafatti JOD, Moreira AJ, Paris EC, Cardenas Flechas LJ, Pereira OAP, Rincón Joya M. Evaluation of Ni-Doped Tricobalt Tetroxide with Reduced Graphene Oxide: Structural, Photocatalysis, and Antibacterial Response. Catalysts. 2022; 12(10):1199. https://doi.org/10.3390/catal12101199
Chicago/Turabian StyleMalafatti, João Otávio Donizette, Ailton José Moreira, Elaine Cristina Paris, Leydi Julieta Cardenas Flechas, Otávio Augusto Poli Pereira, and Miryam Rincón Joya. 2022. "Evaluation of Ni-Doped Tricobalt Tetroxide with Reduced Graphene Oxide: Structural, Photocatalysis, and Antibacterial Response" Catalysts 12, no. 10: 1199. https://doi.org/10.3390/catal12101199
APA StyleMalafatti, J. O. D., Moreira, A. J., Paris, E. C., Cardenas Flechas, L. J., Pereira, O. A. P., & Rincón Joya, M. (2022). Evaluation of Ni-Doped Tricobalt Tetroxide with Reduced Graphene Oxide: Structural, Photocatalysis, and Antibacterial Response. Catalysts, 12(10), 1199. https://doi.org/10.3390/catal12101199

